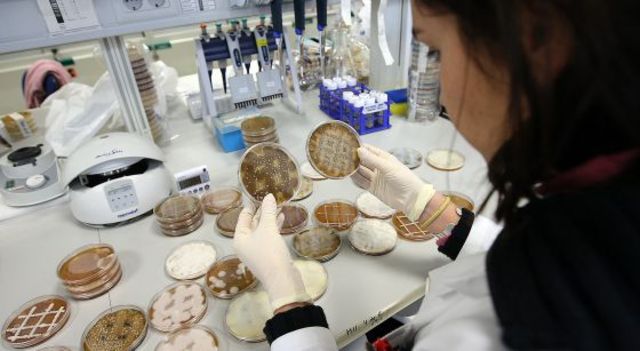
BIOTECNOLOGÍA

-
La aparición de la moneda supuso valorizar mucho más las cosas, ya que en vez de usar el truque se intercambiaba el alimento o lo que fuese por moneda, es decir se le daba un precio a las cosas. De modo que ahí ya generaban un comercio en el que se compraban cosas que alguien fabricaba o producía.
Podemos decir que nuestro sistema ecnómico actual de moneda viene heredado desde hace muchísimos años. -
En este época predominaba el autoconsumo o los productos artesanales por lo que no destaca la industria en sí. La caza y la recolección era una manera de conseguir el alimento, ya que no se acudía a comprarlo. Además ropa (textil) la hacían ellos mismo con pieles de animales, por lo que tampoco necesitaron la industria textil. Hacían todo de forma muy rudimentaria hasta que aparecieron los gremios, esos pequeños talleres donde vendían sus propios productos artesanales.
-
Los gremios eran una agrupación de personas que trabajaban en un mismo oficio, estas se reunian y ponían leyes y normas a su oficio, para que todos estuvieran en las mismas condiciones.
Ya por esta época los productos se fabricaban artesanalmente y se vendían al consumidor. La creación de los gremios supuso crear como pequeñas tiendas - taller en las que se vendía lo elaborado por ellos mismo sin necesitar una gran industrialización. -
GREMIOSEste fue unos de los descubrimientos más importantes de toda la historia, y realmente tiene mucho que ver con la industria y la comercialización. Gracias a este descubrimiento se pudo ampliar el comercio marítimo y además se contruían grandes barcos para poder atravesar los mares.
También el descubrimiento suposo el encuentro de nuevas materias primas extravagantes tanto para alimentos como ropa y materiales. -
La máquina de vapor esta formada por un motor de combustion externa, gracias a esta máquina que funciona media el calentamiento del agua se ha elevado una gran expansión economica. Esta máquina de vapor fue inventada por James Watt quién a través del carbón, una fuente de energía muy importante en esta revolución consiguió hacer las comunicaciones mas fluidas. De modo que se desarrolló el ferrocarril, un aparato enorme que llevaba en su interior una máquina de vapor.
-
Edward Cartwright inventó el telar mecánico. Este descubrimietno fue muy importante para el desarrollo de la industria y probablemente esto llevó a que empezasen a crear las primeras industrias textiles. Estos telares mecánicos funcionan con fuerza hidraúlica.
-
La primera revolución industrial se localizó principalmente en Inglaterra (Gran Bretaña). La principal fuente de energía fue el carbón, que sería el principal combustible de aquella época generando vapor. La tecnología de la época fue principalmente la máquina de vapor que permitió el transporte mediante el ferrocarril de un lugar a otro con mayor rapidez. A nivel de comunicación fue muy importante el invento del telégrafo.
Las primera industrias fueron las textiles, metalúrgicas y siderúrgica. -
La pila es un generador que convierte energía química en energía eléctrica. Es algo que habitualmente usamos con frecuencia, pero realmente tiene un gran uso desde hace muchísimos años. Este es una de los eventos que demuestran el tratamiento de la electricidad en la primera revolución industrial, aunque realmente la electricidad en sí se desarrollase más tarde. El ingenio de fabricar esta pila fue de Alessandro Giuseppe.
-
Philippe Lebon fue el inventor de la lámpara de gas. Estas eran unas pequeñas lámparas que servían para iluminar pequeños espacios. Este fue un invento bastante importante hasta que se desarrolló mucho más la electricidad y sustituyó a esto.
-
El inventor del barco de vapor fue John fitch, gracias a su profesión pudo crear el primer prototipo de barco de vapor en 1787.
El barco de vapor supuso un gran avance a la navegación, gracias al vapor ya no dependían de de las fuerzas del viento o de las corrientes pera desplazarse, con todo esto ganamos también un ahorro de tiempo. -
La locomotora de vapor fue creada el 25 de julio en 1814 por George Stephenson. La locomotora de vapor conseguía arrastrar una carga de cuarenta toneladas a una velocidad de seis kilómetros por hora.
-
El telégrafo es un dispositivo que utiliza señales eléctricas para la transmisión de textos gracias a líneas inalámbricas.
Fue una gran revolución ya que sustituyó a varios sistemas comunicativos como la señales ópticas de semáforo. Y además supuso una mejora de la comunicación y cercanía de la sociedad.
El inventor de esta genial idea para la comunicación fue Samuel Morse. -
El Belga Etienne patentó el primer motor a explosión. El motor de combustión consistía en la explosión de un combustible provocada mediante una chispa, para empujar así un pistón. Los primeros coches se fabricaron salieron el mercado con este tipo demotor, aunque años después se comercializaría otro motor también.
-
Esta revolución se localizó en EEUU, Japón y Europa Occidental.La fuentes de energía usadas en esta revolución fueron el petróleo y la electricidad. La tecnología de la época sería el coche, el avión, la radio y la televisión que es lo que se usaría para comunicarse a través de transporte e información. Las primera industrias serían de motor de explosión, industria química, siderúrgica, producción de automóviles...
-
El pirmer suministro de luz eléctrica de la historia se instaló en la ciudad de New York. Esta creación marcó el incio de la culminante carrera de Edison, ya que apartir de aqí comenzaría a mostrar todos sus descubrimientos y ha enriquecerse.
Estas centrales eléctricas se fueron extendiendo por muchas ciudades, aunque posteriormente fueron desplazadas por un mejor prototipo de Kinola Tesla y George Westinghouse. -
<ahref='http://www.educar.org/inventos/transportes/automovil.asp' >El primer automóvil </a>de la historia que surgió con la segunda revolución industrial y que además fue impulsado por energía petrolífera salió al mercado en 1886. Además fue la marca Carl Benz la que patentó este primer automóvil.
El automóvil alteró la forma de vivir, las ciudades y el paisaje ya que daba otra visión de vida puesto que de forma individual podemos transportarnos a cualquier lugar. Además el automóvil se convirtió en el producto industrial por excelencia. -
El cinematógrafo fue presentado a la sociedad en el Gran Café de Paris. Este aparato permitía la proyección en una pantalla de numerosas escenas animadas, con la vida y moviemiento de la realidad.
Uno o dos años después se comienza a comercializar este producto. -
A finales del siglo XIX el italiano Guillermo Marconi presentó la invención desu radio, y además esta tuvo gran transcendencia pública.
Aunque realmente la primera patente la presentó en 1896, la cual después mejoró.
La radio consiste en la emisión recepción del sonido a través de ondas electromagnéticas. Este aparto supuso en gran cambio para la sociedad, sobre todo para estar enriquecidos de informarción a cualquier hora del día. Además a día de hoy sigue siendo un aparato muy utilizado. -
El primer aeroplano fue inventado por los hermanos Wright y fue el primer objeto más pesado que el aire capaz de volar y tripulado por un hombre
Esto supuso obviamente un gran cambió en la comunicación entre lugares, ya que llegaba mucho antes que en tren a todos los lugares, lo que quizás su coste era más elevado.
De todos modos al principio no se le daba un uso de colectivo hasta que recibió mejoras. -
El escocés John Logie Baird consiguió emitir las primeras imágenes por televisión. El único incoveniente es que su invento causaba ciertos dolores de cabeza al visualizar las imágenes. Así que fue realmente Vladimir Zworykin quien inventó el primer televisor del que derivan todas nuestras teles.
También el méxicano Guillermo González fue el que trajo las imágenes a color a nuestra televisión. -
Tal día como el dos de diciembre un grupo de físicos nucleares ponían en marcha la primera reacción nuclear en cadena. Como objetivo se tenía que por primera vez el hombre fuera capaz de aplicar la energía nuclear. Para esta se usó átomos de uranio, un reactor de estructura sencilla y grafito. Esta primera toma de contacto con la energía nuclear generaría diferentes usos que dar a esta.
La energía nuclear es actualmente algo que nos ayuda a ahorrar energía eléctrica con las centrales nucleares. -
Esta revolución tuvo lugar en EEUU, Japón, EU... Las principales fuentes de energía fueron el petróleo, las energías alternativas y la energía nuclear. Las principales industras fueron de microelectrónica, informática y biotecnología. Fueron tecnologías importantes el tren a alta velocidad, vehículos alimentados de biocarburantres y la continuación y mejora de la energía eléctrica. Podemos decir que el invento más importante fue el internet que se convirtió en una gran fuente de comunicación.
-
La fibra óptica es hoy en día una de las cosas que más necesitamos para nuestro comunicación, y que su llegada a este uso fue muy revolucionaria. Quizás pensamos que la fibra óptica es algo novedoso que llegó a nuestro sociedad hace poco tiempo, pero realmente las primeras fibras ópticas se inventaron en 1952 por el físico Singh Kapany.
De alguna manera la fibra óptica es un material transparente, de carácter plástico por el que se envían pulsos de luz que representan los datos a transmitir, -
A esta red creada en 1969 se le atribuyó el nombre de ARPANET. Este supuso un avance muy importante para las comunicaciones, pero únicamente existían cuatro servidores ubicados en diferentes lugares. Podríamos decir que en esta fecha se creó la red de internet más rudimentaria y que con el paso de los años esta ha ido avanzando hasta tener millones de servidores, haciendo así que nuestra sociedad dependa en gran parte del INTERNET
-
La biotecnología es una ciencia que estudia y aprovecha las interacciones biológicas de los seres vivos. Y se podría decir que es la tecnología basada en la biología. Esta ciencia se utiliza para la creación de alimentos, productos químicos, procesos agrícolas y algunos aspectos marinos.
En 1978 se fundó la que a día de hoy es la empresa biotecnológica más antigua del mundo. Esta se llamó Biogen Idec y se fundó en EEUU.
A día de hoy en la mayoría de los países existen diversidad de empresas. -
Las energías fueron algo muy importante con respecto a las energías de la tercera revolución industrial. Ya que se mostraba una manera más limpia, renovables, inagotable y ligera de consguir energía para un posterior sufructo.
Estas energías fue algo que necesito un previo desarrollo, y que poco a poco han ido mejorando y actualizándose hasta la actualidad. No fue hasta 1984 cuando se pudo tener en Españala primera instalación fotovoltaica conectada a una red piloto. -
En 1992 se inauguró la primera línea de alta velocidad en España. Este era un tren que podía alcanzar una velocidad máxima de 300k/h. Este fue uno de los cambios más significativos con respecto a las comunicaciones ya que permitió la cercanía en menos tiempo de varios lugares españoles. Además se puede notar una gran diferencia con respecto al primer tren de ferrocarril que se creo.
-
MICROELECTRÓNICAAunque se sabe que los primeros descubrimientos de la microelectrónica surgieron en 1947 realmente empezó a comercializarse y ser más reconocida en el año 1995., donde se convirtió en el sector industrial de mayor crecimiento en Europa. Además a partir de ese entonces comenzaría a ser una industria de las más grandes de este siglo, puesto que avances de la microelectrónica es lo que nos ha permitido tener los aparatos electrónicos más revolucionarios.